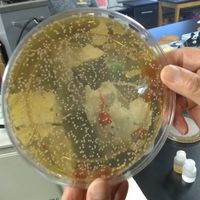

You must be logged in to see Phillip Nichols's about summary.
Contact & Other Info
You must be logged in to see Phillip Nichols's contact details.
Education
You must be logged in to see Phillip Nichols's education details.
Experience
You must be logged in to see Phillip Nichols's work experience details.